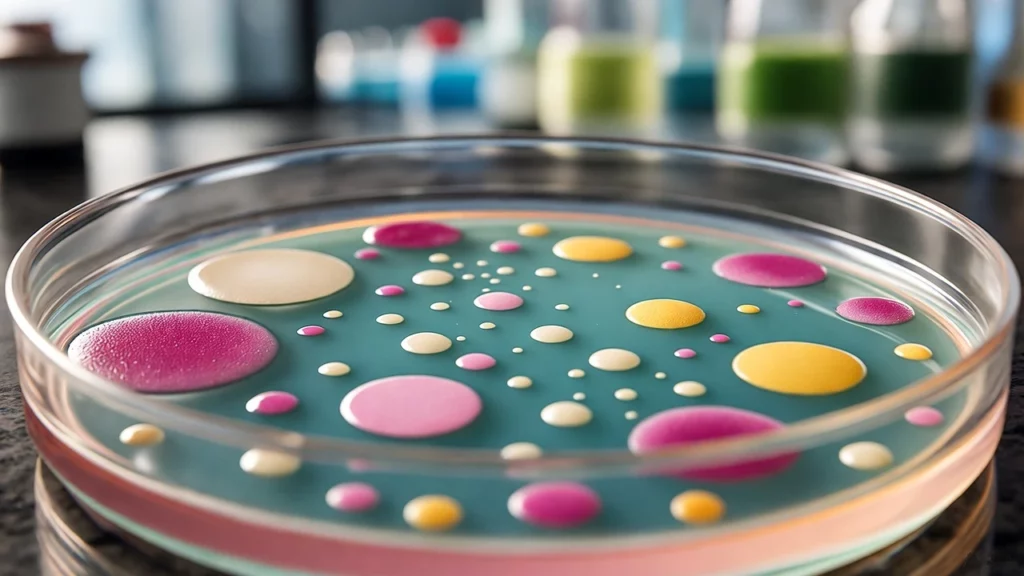
Colourful fungal and bacterial colonies in various shades of pink, yellow, and white growing on a petri dish in a lab

Imagine you’ve got a new batch of plant medicine, like kratom or some other herbal-based supplement, and there’s a lab report staring you in the face. It’s full of terms like CFU/g, microbial limits, and a bunch of microbe names that sound like a science quiz. The “microbial screening” section grabs your attention, and you’re thinking: what are these lab tested microbes, and why do they matter? If you’ve ever been confused by those reports, don’t worry, this blog breaks it down so you can understand what’s going on and feel confident about what you’re using.
What Exactly Are Lab Tested Microbes?
So, what are lab tested microbes? They’re tiny organisms, bacteria, fungi, or other microscopic life, that labs check for to make sure your herbal product isn’t carrying anything sketchy. These microorganisms can sneak onto plants from soil, water, or even someone’s hands during processing. In plant medicines, where you’re dealing with raw, natural stuff, testing for these microbes is a must to keep things safe.
How Microbes Get Into Plant Medicines
Picture a plant’s journey from a field to your kitchen. It grows in soil full of microscopic life, gets picked, dried, ground up, and packed. Along the way, microbes can jump on board, maybe from wet leaves, dusty air, or sloppy handling. Labs use tools like plate counts or DNA tests to spot these microbes, measuring colony-forming units per gram (CFU/g), which just means how many could grow from a sample. For herbs, safe levels are usually under 10,000 CFU/g for total counts and zero for anything dangerous. Think of it as a quality check to make sure your product is good to go.
Why Microbial Testing Keeps Things Safe
Why bother with lab tested microbes? Plants used in medicines grow in soil teeming with microscopic life, so contamination from bacteria or fungi is a real risk. Testing catches harmful microbes, like pathogens causing illness or molds producing toxins, before they reach you. Labs follow strict health standards, ensuring only safe products hit the market. Regular checks also verify clean processing, from harvest to packaging, giving you confidence in the purity and safety of your herbal supplements.
How Labs Check for Microbes
Before we dive into the microbes, here’s a quick look at how testing works. Labs might spread a sample on nutrient gel plates and let it sit to see what grows, or they use PCR tests to spot microbial DNA fast. Results show counts or confirm absences, with strict safety limits set by health authorities. It’s like running your product through a security scanner, thorough and reassuring when it comes back clean. Now, let’s get to the first microbe.
Salmonella: The Sneaky Contaminant
First up on our list of lab tested microbes is Salmonella, a bacterium you might know from food safety warnings. It’s not just about undercooked chicken, it can show up in plant medicines through dirty water or soil. Salmonella’s a rod-shaped bacterium thriving in warm, wet conditions, like leaves that didn’t dry properly.
It’s a problem because it’s a pathogen that can make you sick, with symptoms like diarrhea, fever, or cramps. For most, it’s a rough few days, but for kids, older folks, or those with weaker immune systems, it can get serious. In herbs, it often comes from animal waste in irrigation or soil. Labs test for it since even a tiny amount (above zero CFU/g) can lead to recalls.
On a lab report, you want “Absent” or “Not Detected” for Salmonella. Anything else means the batch is off-limits. It’s like checking your fridge for expired food, catch it early, avoid trouble. Processors use clean water and proper drying to keep Salmonella out, and testing seals the deal.

E. coli: The Warning Sign
If Salmonella’s sneaky, Escherichia coli, known as E. coli, is the red flag in the microbial world. Most E. coli strains are harmless and some help your gut digest food. But the ones labs test for, like O157:H7, can cause problems, from severe diarrhea to kidney issues.
In plant medicines, E. coli often points to fecal contamination, maybe from livestock runoff or unwashed hands during harvest. It’s a rod-shaped bacterium thriving in warm, moist spots, so drying herbs quickly is key. On lab reports, look for “E. coli <10 CFU/g” or “Absent.” Higher counts mean hygiene issues, like a check-engine light for your car.
E. coli’s a warning buzzer, signaling broader sanitation problems. Farms in wet climates might struggle, but clean water systems and training keep it under control. Low E. coli counts show a supplier’s got things handled.
Total Coliforms: The Hygiene Check
Shifting to a broader group, total coliforms are lab tested microbes that act like a hygiene meter. This group includes E. coli and other gut bacteria, some harmless, some not. They’re gram-negative rods, often lactose-fermenters, showing up in herbs from soil or water issues.
Labs test coliforms because they’re easy to spot, pink colonies on plates give them away. Counts over 100 CFU/g might mean dust from grinding or bad storage. They’re not always dangerous, but high levels hint at other problems. On reports, you want “Total Coliforms <100 CFU/g.” It’s like checking if a kitchen’s clean, low counts mean everything’s in order. Good facilities and tight packaging keep coliforms low, so you can trust the product.
Enterobacteriaceae: The Bigger Hygiene Clue
A step up from coliforms, Enterobacteriaceae is a larger family of lab tested microbes, including Salmonella, E. coli, and others like Klebsiella. These gram-negative bacteria live in guts and environments, signaling how clean the process is.
In plant medicines, high Enterobacteriaceae counts (over 1,000 CFU/g) could come from soil dust or water splashes. They’re not all bad, but too many suggest the supply chain needs work. Labs use special media to count them, tying results to total plate counts. Think of Enterobacteriaceae as a big family reunion, some members are fine, others are trouble, and too many mean things are off. Low counts show the production line’s running smoothly.
Yeast: The Fungi That Can Overstay
Moving to fungi, yeast is a single-celled organism that makes bread rise and beer ferment but can cause issues in plant medicines. Species like Saccharomyces or Candida float in the air or stick to damp leaves, growing fast if drying’s slow.
In lab tested microbes, yeast counts above 100 CFU/g can mean wet storage, causing weird tastes or, rarely, infections for those with weak immune systems. Most folks handle low levels okay, but allergies can act up. Labs grow them on plates at room temperature, aiming for under 1,000 CFU/g with mold. Yeast’s like a guest who’s fun in small doses but annoying if they linger. Quick, dry processing, like airing out a damp room, keeps them in check. Low yeast counts mean your product’s fresh.
Mold: The Fungi That Spoils
Mold, another key in lab tested microbes, is yeast’s multicellular cousin. Think Aspergillus or Penicillium, spreading via spores in thread-like networks. In plant medicines, molds thrive in humid conditions, especially in tropical areas.
The issue? Some molds make mycotoxins, like aflatoxins, harming your liver over time. Even non-toxic molds above 100 CFU/g can cause allergies or breathing problems. Labs report “Yeast and Mold <1,000 CFU/g,” flagging risky molds. Mold’s like food left in the fridge too long, one oversight, and it’s fuzzy. Fast drying and controlled storage stop it. Low mold counts feel like opening a fresh package every time.

Fungal Contaminants: The Wider Risk
Beyond yeast and mold, “fungal” covers a broader range of lab tested microbes, like Fusarium or Rhizopus, often from soil. These fungi can contaminate herbs during growth or storage, especially in warm, damp climates.
Unlike specific molds, fungal screening catches outliers that might not be toxic but can mess with quality, think off smells or weaker potency. High counts (over 1,000 CFU/g) point to issues like poor ventilation. Labs use fungal plates or DNA tests to spot them. Fungal contaminants are a wildcard, tricky but manageable with care. Low counts mean the product’s been handled right, keeping nature’s messiness in check.
Fecal Contaminants: The Big Red Flag
Next up in lab tested microbes is fecal contaminants, a group covering bacteria from animal or human waste, like Shigella or Campylobacter, beyond E. coli. In plant medicines, they sneak in through dirty water, soil, or handling mistakes.
Fecal contaminants are a hard no, any detection (above 0 CFU/g) means the batch is out. They can cause stomach issues to infections. Labs use targeted tests, like special agar for Shigella, to confirm they’re not there. Think of fecal contaminants as a health inspector’s worst day, a sign things need fixing. Clean irrigation and strict hygiene block them. A “Not Detected” result is your all-clear.
Staphylococcus aureus: The Human-Sourced Risk
Not all lab tested microbes come from nature, Staphylococcus aureus, or Staph, comes from human skin or noses. This round, grape-like bacterium is usually harmless but can produce toxins causing food poisoning or skin infections if it grows.
In herbs, Staph gets in during handling, like someone sorting leaves without gloves. It’s tough, surviving drying, and grows without oxygen. Labs want zero toxin-producers or under 100 CFU/g. Golden colonies on plates show it’s there. Staph’s like a coworker who’s fine at a distance but a problem up close, gloves and sanitizers keep it out. No Staph in results means careful handling.
Total Aerobic Microbial Count: The Big Picture
Rounding out our nine lab tested microbes is the Total Aerobic Microbial Count (TAMC), a tally of oxygen-loving bacteria and fungi, like Bacillus from soil. It’s not one microbe but a snapshot of the product’s microbial load. High TAMC (over 10^5 CFU/g) might mean dusty milling or loose packaging, even if pathogens aren’t there. Safe levels for herbs are under 10^3 to 10^5 CFU/g. Labs grow samples on agar at 30-35°C to count them. TAMC’s like your car’s dashboard light, green’s good, yellow means check it out. It wraps up the microbial picture, ensuring everything’s balanced.
Summary of 9 Key Lab Tested Microbes in Plant Medicines
| Microbe/Group | Type | Common Source | Health Risk | Safe Lab Result |
|---|---|---|---|---|
| Salmonella | Bacterium | Dirty water, soil | Diarrhea, fever | Not Detected |
| E. coli | Bacterium | Fecal contamination | Severe diarrhea, kidney issues | <10 CFU/g or Absent |
| Total Coliforms | Bacterial group | Soil, water | Hygiene issues | <100 CFU/g |
| Enterobacteriaceae | Bacterial group | Soil, water | Hygiene issues | <1,000 CFU/g |
| Yeast | Fungus | Air, damp leaves | Off-flavors, allergies | <1,000 CFU/g (with mold) |
| Mold | Fungus | Humid conditions | Mycotoxins, allergies | <1,000 CFU/g (with yeast) |
| Fungal Contaminants | Fungal group | Soil, poor ventilation | Quality issues, allergies | <1,000 CFU/g |
| Fecal Contaminants | Bacterial group | Waste, dirty water | Stomach issues, infections | Not Detected |
| Staphylococcus aureus | Bacterium | Human handling | Food poisoning, skin infections | <100 CFU/g or Absent |
| Total Aerobic Microbial Count | Mixed group | Soil, dust | High bioburden | <10^3 to 10^5 CFU/g |
Note: Always check lab reports for recent dates and accreditation (e.g., ISO standards) to ensure reliable results for lab tested microbes.
Frequently Asked Questions About Lab Tested Microbes
Q: How often should plant medicines be tested for microbes?
A: It depends on the supplier, but good ones test every batch before it ships. This keeps things safe, especially since herbs from different climates can vary. Testing monthly or per harvest catches changes in lab tested microbes.
Q: Can I trust a lab report if it’s not from an accredited lab?
A: It’s dicey. Accredited labs, like those with ISO standards, use reliable methods to detect lab tested microbes. Non-accredited ones might miss stuff or get counts wrong, so check for certifications on the report.
Q: What happens if a product fails a microbial test?
A: If lab tested microbes like Salmonella or fecal contaminants are too high, the batch usually gets tossed or destroyed. Suppliers might also check their process, like fixing dirty water sources, to avoid it happening again.
Q: Are all microbes in plant medicines harmful?
A: Nope. Many lab tested microbes, like some in the Total Aerobic Microbial Count, are just harmless soil bacteria. Only pathogens like E. coli or toxic molds are trouble, which is why tests focus on them.
Q: How can I tell if a lab report is recent?
A: Look for the test date on the certificate of analysis. It should be within a few months of your purchase to reflect the batch’s safety. Old reports might miss new issues with lab tested microbes.
Conclusion: Knowing Your Lab Reports Makes a Difference
We’ve covered nine key lab tested microbes, from Salmonella’s sneaky ways to TAMC’s overall check. Each one helps ensure plant medicines are safe and clean. Why’s this a big deal? Understanding these tests lets you make sense of lab reports and feel good about what you’re using. Check for “Not Detected” on pathogens, low counts elsewhere, and recent dates from accredited labs, ISO’s a nice bonus.
With plant medicines, purity takes work. This knowledge helps you ask the right questions about sourcing and choose products with confidence. Next time you see a lab report, you’ll know it’s your guide to quality, cutting through the complexity of nature.
Disclaimer
The information provided in this blog about lab-tested microbes in plant-based supplements, such as herbal powders, is intended for educational and informational purposes only and should not be considered medical or professional advice. While microbial testing helps ensure product safety, the presence or absence of specific microbes does not guarantee a product is free from all risks or suitable for individual use.
Consuming plant-based supplements may carry health risks, including allergic reactions, interactions with medications, or adverse effects, particularly for individuals with compromised immune systems, chronic illnesses, or specific medical conditions. Always consult a qualified healthcare professional before using any herbal or plant-based supplement to ensure it is safe and appropriate for your health needs.
The microbial limits and safety standards mentioned, such as CFU/g thresholds, are general guidelines and may vary based on regional regulations or specific product requirements. Users should verify lab reports from accredited laboratories and confirm compliance with local health authority standards. Neither the author nor publishers are liable for any health, safety, or medical issues arising from the use of products based on this information. Proceed with caution and prioritize professional medical guidance when making decisions about supplement use.